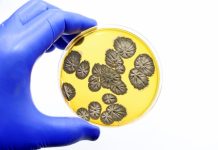
Biomarkerul Sanguin Care Prevestește Infecțiile Fungice Grave

Plantele care adoră căldura și prosperă în Valea Morții din California ar putea deține cheia pentru cultivarea plantelor într-un climat în schimbare.
Cercetătorii au descoperit recent cum o plantă neobișnuită de deșert reușește să prospere într-unul dintre cele mai fierbinți locuri de pe Pământ. Se pare că acest tufiș rezistent își rearanjează structura internă atunci când temperatura crește.
Valea Morții din California se confruntă frecvent cu condiții extreme. Temperaturile de vară depășesc adesea 49 de grade Celsius în umbră. Majoritatea plantelor se ofilesc în fața unui asemenea căldurii, dar Tidestromia oblongifolia, un tufiș cu flori gri-verzui, prosperă.
Cercetările recente arată că aceste tufișuri își micșorează frunzele și își rearanjează structura internă pentru a înflori în condiții extrem de calde. De asemenea, s-a descoperit că acest tufiș are cea mai bună toleranță fotosintetică la căldură dintre toate plantele cunoscute, adică capacitatea de a fotosintetiza la temperaturi înalte.
Studiul a fost publicat pe 17 noiembrie în revista Current Biology.
Schimbările climatice cresc temperaturile globale și intensifică frecvența valurilor de căldură. Căldura reduce deja randamentele culturilor de bază, cum ar fi grâul și porumbul, iar oamenii de știință și oficialii sunt preocupați de ce înseamnă acest lucru pentru securitatea alimentară pe măsură ce temperaturile continuă să crească.
Plantele care iubesc căldura, cum ar fi T. oblongifolia, ar putea deține secretele pentru a ajuta alte plante să supraviețuiască căldurii și să mențină alimentele pe mesele oamenilor. “Înțelegerea adaptărilor lor ar putea ajuta cercetătorii să proiecteze culturi, medii și strategii de gestionare pentru a îmbunătăți creșterea sub temperaturi din ce în ce mai ridicate și prelungite,” a declarat Seung Rhee, co-autor al studiului și director al Institutului de Reziliență a Plantelor de la Universitatea Statului Michigan, pentru Live Science.
De decenii, oamenii de știință știu că există ceva special la T. oblongifolia. La temperaturi mai ridicate, rata fotosintezei majorității plantelor scade. Dar în 1972, cercetătorii au arătat că fotosinteza T. oblongifolia atinge un vârf la 47 °C. Pentru a afla cum supraviețuitorul rezistent poate continua să fotosintetizeze și să prospere în timp ce alte plante se ofilesc, cercetătorii din spatele noului studiu au colectat semințe din Valea Morții și au crescut plantele în containere de creștere. După opt săptămâni, plantele au fost supuse condițiilor din Valea Morții timp de o lună, observându-se răspunsurile lor, cum ar fi cantitatea de dioxid de carbon absorbită.
În doar două zile, T. oblongifolia și-a intensificat rata fotosintezei. După 10 zile, și-a triplat biomasa printr-o profuzie de frunze mai mici decât cele pe care le produce la temperaturi mai scăzute.
Dar schimbarea cu adevărat surprinzătoare a avut loc în interiorul plantei. Cercetătorii au descoperit că aceasta a dezvoltat mai multe mitocondrii, care sunt centralele energetice — sau bateriile — din interiorul celulei. Aceste mitocondrii erau de asemenea mai
Poll: Care este impactul descoperirii plantelor care se adaptează la temperaturi extreme în Valea Morții din California asupra producției alimentare viitoare?

Leave a Reply